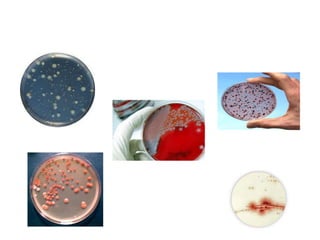

Le document présente une introduction à la microbiologie et aux micro-organismes, qui sont des organismes vivants microscopiques, notamment des bactéries, des protozoaires, et des champignons. Il aborde aussi l'évolution historique de la microbiologie, la classification des organismes vivants, ainsi que les relations entre les micro-organismes et les êtres vivants, en incluant leur rôle écologique et leur importance en médecine et en biotechnologie. Enfin, il explique la structure, la fonction et la reproduction des protistes.